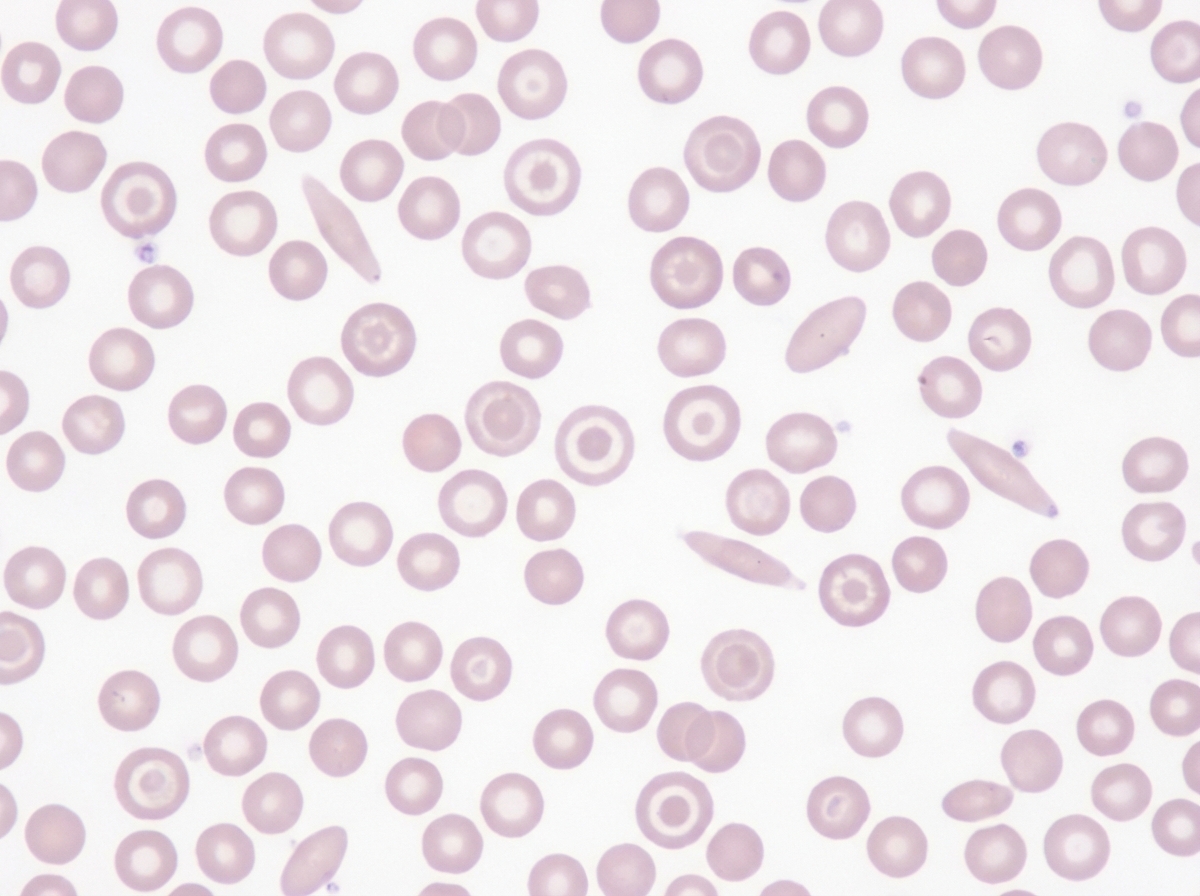
Image for question 317

Enter your email to get your 85% OFF code and unlock the full USMLE question bank on the app.
A 34-year-old man comes to the physician for evaluation of a rash on the elbows for several months. A biopsy of the affected area shows a thinned stratum granulosum as well as retained nuclei and spongiotic clusters of neutrophils in the stratum corneum. This patient's skin findings are most likely associated with which of the following conditions?
A 55-year-old male presents to his primary care physician with right upper quadrant pain that has progressed over the last three months with unexplained weakness and joint pains that have been "out of the ordinary" over the last year. On history, you note the patient lives a sedentary lifestyle, rarely leaves the house, has controlled diabetes diagnosed 15 years ago, and has documented cardiomyopathy. On physical exam the man appears non-toxic, sclera are icteric, cornea appear normal, generalized pain is elicited on palpation of the right upper quadrant, and skin appears quite bronzed on his extremities. What is this patient most at risk for ten to fifteen years later due to his underlying condition?
A 47-year-old woman comes to the physician for a 2-month history of fatigue, intermittent left-sided flank pain, and diffuse extremity pain. She was treated for a prolactinoma 5 years ago and has had recurrent antral and duodenal peptic ulcers despite medical therapy. Her only medication is omeprazole. Physical examination shows a moderately distended abdomen that is diffusely tender to palpation. There is mild left-sided costovertebral angle tenderness. Serum studies show a calcium of 12 mg/dL, phosphorus of 2 mg/dL, and parathyroid hormone level of 826 pg/mL. An ultrasound of the abdomen shows multiple kidney stones in the left ureteropelvic junction. This patient is most likely to have which of the following protein abnormalities?
A 51-year-old woman with Sjogren’s syndrome presents to her physician for suddenly developed palpitations. She feels more anxious than usual and has had difficulty sleeping well for the past 2 weeks. She has lost 2 kg (4.4 lb) since her last routine appointment 6 months ago. She also has had diarrhea and often feels like her heart is beating very quickly. On physical examination, her skin appears warm and moist. Her reflexes are hyperactive. Her thyroid is moderately enlarged and is non-tender. She has mild dry eyes and dry mouth. Her blood pressure is 136/88 mm Hg, pulse is 76/min, respirations are 17/min and temperature is 36.7°C (98.1°F). Which of the following pathologic findings is this patient likely to have?
An otherwise healthy 17-year-old girl comes to the physician because of multiple patches on her face, hands, abdomen, and feet that are lighter than the rest of her skin. The patches began to appear 3 years ago and have been gradually increasing in size since. There is no associated itchiness, redness, numbness, or pain. She emigrated from India 2 years ago. An image of the lesions on her face is shown. Which of the following is most likely involved in the pathogenesis of this patient's skin findings?

An investigator is studying the outcomes of a malaria outbreak in an endemic region of Africa. 500 men and 500 women with known malaria exposure are selected to participate in the study. Participants with G6PD deficiency are excluded from the study. The clinical records of the study subjects are reviewed and their peripheral blood smears are evaluated for the presence of Plasmodium trophozoites. Results show that 9% of the exposed population does not have clinical or laboratory evidence of malaria infection. Which of the following best explains the absence of infection seen in this subset of participants?
A 24-year-old Turkish female presents to your office for a routine examination. She recently started a new job and has been tired most of the time. She does not have any dizziness and has not lost consciousness. She follows a well-balanced diet and is not vegetarian. She recalls that other family members have had similar symptoms in the past. On physical exam her temperature is 99°F (37.2°C), blood pressure is 115/78 mmHg, pulse is 100/min, respirations are 22/min, and pulse oximetry is 99% on room air. On physical exam, you notice conjunctival pallor. Labs are obtained and the results are shown below: Hemoglobin: 10.2 g/dL Hematocrit: 34% Leukocyte count: 5,000 cells/mm^3 with normal differential Platelet count: 252,000/mm^3 Mean corpuscular hemoglobin concentration: 20.4% Mean corpuscular volume: 65 µm^3 Peripheral blood smear is shown in the image provided. The cause of her anemia is most likely associated with which of the following?
A four-year-old boy is brought to his pediatrician by his mother for recurrent nosebleeds. The mother reports that the boy has had five nosebleeds within the past 2 weeks, each lasting between 15 and 20 minutes. The patient was born at term and has been hospitalized twice for pneumonia treatment. There is no family history of serious illness. The patient is at the 8th percentile for height and the 30th percentile for weight. Vital signs are within normal limits. Examination shows a small, thin child with two flat, dark brown areas of hyperpigmentation across the upper back and a similar discoloration on the left buttock. There is bilateral esotropia. Laboratory studies show a hemoglobin concentration of 9.3 g/dL, mean corpuscular volume of 107 μm3, leukocyte count of 3,800/mm3, and platelet count of 46,000/mm3. Which of the following is the most likely underlying cause of this patient's condition?
A 29-year-old woman presents with shortness of breath and chest pain for the past week. She says her chest pain is aggravated by deep breathing and she becomes short of breath while walking upstairs in her home. She also has been feeling feverish and fatigued for the past week, as well as pain in her wrists, hands, and left knee. Review of systems is significant for a 4.5 kg (10.0 lb) weight loss over the previous month. Past medical history consists of 2 spontaneous abortions, both of which occurred in the 1st trimester. On physical examination, there is a pink rash present over her face, which is aggravated by exposure to sunlight. There are decreased breath sounds on the right. A chest radiograph is performed which reveals evidence of a right pleural effusion. Serum ANA and anti-dsDNA autoantibodies are positive. Urinalysis is unremarkable. Errors with which of the following is most likely to lead to her disease?
A 51-year-old African American man presents to his primary care physician’s office for an annual visit. He has no major concerns and says that he has been healthy for the last year. His past medical history is significant for diabetes as well as long standing hypertension that has developed gradually since his 30's; however, he has refused to take any medications. Physical exam shows no abnormal findings. Routine laboratory testing reveals the following: Serum creatinine concentration: 1.5 mg/dL Blood urea nitrogen: 31 mg/dL Based on these results, urine studies are conducted that reveal mild proteinuria of less than 1 g/day and no casts. Which of the following is most likely associated with the cause of this patient's elevated creatinine?
Liver pathology (hepatitis, cirrhosis)
Practice Questions
Gallbladder and biliary tract disorders
Practice Questions
Pancreatic diseases
Practice Questions
Kidney diseases
Practice Questions
Male reproductive pathology
Practice Questions
Female reproductive pathology
Practice Questions
Breast pathology
Practice Questions
Endocrine pathology
Practice Questions
Bone and joint pathology
Practice Questions
Skeletal muscle diseases
Practice Questions
Peripheral nerve disorders
Practice Questions
Soft tissue tumors
Practice Questions
Head and neck pathology
Practice Questions
Get full access to all questions, explanations, and performance tracking.
Scan to download app